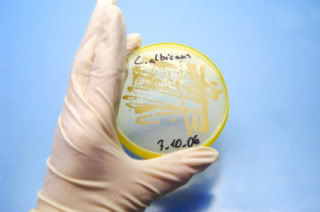

Mark Sisson's Blog, page 371
September 12, 2012
Contest: Make a Primal Blueprint Recipe Video
 The Prize:
The Prize:
I’m giving away a huge assortment today, starting with…
A Primal/paleo Cookbook Library - Just a few years ago it was next to impossible to find a high-quality Primal/paleo/ancestral health cookbook on the market. I set out to change that and released The Primal Blueprint Cookbook in 2010, Primal Blueprint Quick & Easy Meals last year, and I’ve got another Primal cookbook due out this December (more on that this coming Saturday). With the growing popularity of the Primal health movement, other fantastic books have recently been published, too. The lucky winner of this contest will receive every book featured in the pic to the right: Make it Paleo, Practical Paleo, Paleo Comfort Foods, Eat Well Feel Good (order here for $5 off the cover price for MDA readers), The Garden of Eating, Everyday Paleo, Everyday Paleo Family Cookbook, Well Fed (get a 30-page preview of Well Fed here), and Paleo Pals: Jimmy and the Carrot Rocket Ship. I have copies of each of these on my bookshelf and highly recommend them all.
 Tropical Traditions Coconut Package – You probably know we’re crazy for coconut in these parts. That’s why I’m thrilled that Tropical Traditions has donated this coconut-inspired prize package for today’s contest. The lucky winner will get all this delivered to their doorstep: 1 gallon of Gold Label Virgin Coconut Oil ($120 value), a 2.2 lb bag of Organic Coconut Flour ($15 value), a copy of their Virgin Coconut Oil book ($25 value), AND a $100 gift certificate to buy anything you want at TropicalTraditions.com. This package is valued at $260.
Tropical Traditions Coconut Package – You probably know we’re crazy for coconut in these parts. That’s why I’m thrilled that Tropical Traditions has donated this coconut-inspired prize package for today’s contest. The lucky winner will get all this delivered to their doorstep: 1 gallon of Gold Label Virgin Coconut Oil ($120 value), a 2.2 lb bag of Organic Coconut Flour ($15 value), a copy of their Virgin Coconut Oil book ($25 value), AND a $100 gift certificate to buy anything you want at TropicalTraditions.com. This package is valued at $260.
Sign up for Tropical Traditions newsletter here to be alerted of the latest sales and newest products.
Learn the history of Tropical Traditions by watching this video: How We Discovered Virgin Coconut Oil – An Interview with Brian Shilhavy, CEO Tropical Traditions.
And check out their kitchen-tested recipes at their Free Coconut Recipes blog.

Pure India Foods Ghee Package – Pure Indian Foods will be sending one case (12 jars) of 7.8 oz. jars of Grass-fed Organic Ghee (retail value over $130), and one Assorted Sampler Pack containing one 7.8 oz. jar of each of their six Herbal/Spice infused ghee flavors (retail value $89.95) to the lucky winner of this contest.
Pure Indian Foods has just launched the world’s first Grass-fed and Certified Organic Cultured Ghee. This delicious ghee is based on the age-old and time-honored practice of culturing the cream before churning it into butter and then clarifying it into ghee.
Check out Pure Indian Foods on Facebook and take advantage of this special offer: use discount code “PALEO-GHEE” when checking out and receive $10 off any order over $35. Valid until 9/29/2012.

Vibram FiveFingers – If you’re at all familiar with Mark’s Daily Apple, you probably know how much I love these things. I’m so smitten I’ve even teamed up with Vibram to help spread the word about going barefoot. Check out my “day in the life” video here. The winner will get to choose their favorite men’s or women’s style and color.
The Primal Blueprint Platinum Package – The Platinum Package is the ultimate in supplementation and is what thousands of Primal enthusiasts and I take daily. Includes: Damage Control Master Formula, Primal Fuel, Primal Flora, Vital Omegas, and Vitamin D booster. With a 30-day supply of a comprehensive, well-balanced multi-vitamin complex, omega-3 fish oils, healthy probiotics, vitamin D and a delicious, coconut-based Primal meal replacement shake, the Platinum Package is a convenient and cost-effective way to live a healthy, Primal life in the modern world.
The Primal Library, the Tropical Traditions package, the Pure Indian Foods Ghee package, the FiveFingers and the Platinum Package. That’s about $1000 worth of Primal goodies to get you in to the kitchen and cooking…
The Contest:
Create and upload a Primal recipe video to YouTube. Have you mastered the omelet? Are you an almond flour fiend? Maybe your salad is so mean, it can win a chili cookoff. If so, let the world in on your secrets. Grab your camcorder, and show us how to make something Primal. There aren’t really restrictions on how you do it. The only requirement is that your video relates in some way to the Primal Blueprint eating plan. Show the world (how to prepare) your best Primal dish and you could be the winner of the complete Primal package listed above.
For ideas on what you can do, check out these highlights for years past.
Here’s 2009′s winning video, Skinless Gyoza:
Check out all the 2010 submissions here. Here is 2010′s winning video:
Here are the finalists for 2011′s contest, and here is the winning video:
The video needs to be an original creation made for the purposes of this contest.
On YouTube, please title the video “Primal Blueprint Recipe:” followed by your own sub-title.
Upload your video to YouTube and then email me the link. Include the words “Recipe Video Submission” in the subject line of your email. Otherwise, there’s a good chance I may completely miss your submission.
I’ll publish select videos on Mark’s Daily Apple the last week of this challenge.
The Deadline:
September 22, midnight PDT.
Who is Eligible:
This one’s global. Anyone in the world can enter.
How A Winner Will Be Decided:
Video submissions will be posted toward the end of the Challenge. The Worker Bees and I will choose a list of finalists to be voted on by readers.
Fine Print:
MDA reserves the right to publish and/or edit any videos submitted.
We ask that any videos submitted to this contest remain live on YouTube after the challenge for future visitors to Mark’s Daily Apple to enjoy.
To track all the contests visit the 2012 Primal Blueprint 21-Day Challenge Contest Page for daily updates.
Subscribe to the Mark’s Daily Apple Newsletter for Free eBooks, Weekly Challenge Updates and More!

September 11, 2012
Starting from Zero
 With yesterday’s launch of this year’s Primal Challenge, I hope you’re all feeling as pumped and excited as I am. Whatever your biggest goal coming into it (e.g. weight loss, stress management, fitness performance), you’re in great company. Thousands of readers every year find the annual Challenge a powerful catalyst for transforming their well-being. Having made the initial commitment, we’re now on the journey itself. This is where the rubber meets the road, folks. Rush turns to focus. Vision becomes reality one day at a time. For some readers, however, staring down the path might seem especially long and arduous. The road side, so to speak, might be littered with the psychological scraps of past disappointments, long-term illness, or emotional issues. Some folks can feel like they’re starting their journey from a formidable zero.
With yesterday’s launch of this year’s Primal Challenge, I hope you’re all feeling as pumped and excited as I am. Whatever your biggest goal coming into it (e.g. weight loss, stress management, fitness performance), you’re in great company. Thousands of readers every year find the annual Challenge a powerful catalyst for transforming their well-being. Having made the initial commitment, we’re now on the journey itself. This is where the rubber meets the road, folks. Rush turns to focus. Vision becomes reality one day at a time. For some readers, however, staring down the path might seem especially long and arduous. The road side, so to speak, might be littered with the psychological scraps of past disappointments, long-term illness, or emotional issues. Some folks can feel like they’re starting their journey from a formidable zero.
You might be in the worst shape of your life. You might be tipping the scale at an all-time high. You might be fighting a serious health condition you never dreamed you’d encounter. You may have battled disordered eating. You might not remember when/if you ever had a good self-image. My good readers, how many of you felt this way before going Primal? A good percentage of our Friday Success Stories tell this story. An inspiring number of our 2012 Success Stories in the Making reflect the same.
In all my years talking with clients and readers, I’ve heard people often say they’re starting from zero, from rock bottom, with no baseline at all. I understand where they were coming from. Everyone is beginning this journey with a different level of fitness and health. I get that. Yet, I have never in my entire career met anyone starting with nothing. The concept defies physiological reality.
You might get winded walking up half a flight of stairs. You may have lost significant muscle mass. You might struggle to simply sit with (let alone carry) around the extra 50, 75, or 100+ pounds you’ve put on. However, your body is still made to move. It still craves it. I ran across a quote recently “If you have a body, you’re an athlete.” I’d second that. It’s feels harder to train at times, but – make no mistake – living and breathing within you is that pure physical force, that Primal Grok, that evolutionary extraordinaire. Choosing to live Primally – with the right fuel, the expected movement, the necessary sleep and sun – simply allows you to live out the full measure of that vital potential.
And let me say something else about one’s “baseline.” When beginning a journey like this, baseline is about much more than VO2 max, mile time, bench press weight, or lipid profile. Numbers don’t tell your story, and they don’t determine your prospects for success. Think for a minute about what else you bring to the Challenge. What about the motivational power? What about the emotional stamina? What about the social strength of friends, family, and Primal community? What about the force of full-on personal investment or raw will? Those count for something. In fact, those often count for everything. Your physical baseline determines the particular level you start from, but it doesn’t define the trajectory of your journey or the fulfillment of your experience along the way.
Along these lines, let me offer a few suggestions and invite each and every one of our readers to give their own perspective and encouragement.
Invest in Support
As you begin the Challenge, make sure you’re taking full advantage of the support system you have. Not everyone in your life is on board with the Primal Blueprint, it’s true. Regardless, look to those in your life who bring a Primally sympathetic or just open mindset. Some friends, even if they can’t understand why you’re eating so much fat, will support you because they want to simply celebrate any investment you make in your health and happiness. Embrace that. Open yourself to the support of folks in this community. Participate in the comment boards, join the forum, and you’ll see what I mean. Finally, if you feel like past issues like disordered eating still have a grip on you, enlist the professional help you need and deserve.
Develop Big Picture Perspective
Sometimes people get caught up in a particular goal and lose sight of the full process. Embrace daily Primal living and not just specific Challenge goals. (For some people, this might be an important Challenge focus itself.) Going Primal will get you to the destination you have in mind, but it’s not the deprivation-focused, white-knuckle experience you might be used to. Use the Challenge to transform your life as well as you physiology. Relish the myriad of benefits going Primal offers. It’s more than the weight loss and lean muscle mass. Notice the better quality sleep, the more even mood, the sharper focus, the more consistent energy in your day. On that note…
Prioritize Feeling Good (Primally Speaking) Every Day
You’re making a point of eating real, ancestral-worthy food, of adding an exercise regimen. Rest assured, you’re remaking your physiology in the process. You will absolutely reap the benefits long before this Challenge is over. But also make a point of doing something (or several things) that make you feel good today. These healthy “indulgences” can help get you through a rough day of low carb flu or unexpected stress. Relax in the sun. Relish turning in early for a full night’s sleep. (Remember what that feels like?) Share a walk with a good friend you haven’t talked to in a while. Play. Enjoy an old hobby. Take a personal retreat. Make a masterpiece dinner and savor it in real ambiance. In other words, let yourself enjoy the process. Make the Challenge an indulgence as well as an investment in yourself. And make sure you have good Primal fun every day.
Grokkers, please chime in – whether you identify with the “starting from zero” or want to support those who do. What perspective and advice do you have? Thanks for reading today, everyone. Check back tomorrow for the 8 Key Concepts you need to understand for a successful Primal Blueprint 21-Day Challenge.
Subscribe to the Mark’s Daily Apple Newsletter for Free eBooks, Weekly Challenge Updates and More!

Have a Picnic. Win a Cow. The 2012 Grokfeast Challenge.
 It’s cow time. US Wellness has long been a favorite meat spot for MDA readers. A few years ago they donated pemmican and the popular 5 gallon bucket of fat. Last year they went whole hog. And by hog, I mean cow. And they’re doing it again this year. US Wellness has generously offered up a cow to the winners of today’s contest, the Grokfeast Challenge. (More specifically, enough gift certificates to buy an entire cow.)
It’s cow time. US Wellness has long been a favorite meat spot for MDA readers. A few years ago they donated pemmican and the popular 5 gallon bucket of fat. Last year they went whole hog. And by hog, I mean cow. And they’re doing it again this year. US Wellness has generously offered up a cow to the winners of today’s contest, the Grokfeast Challenge. (More specifically, enough gift certificates to buy an entire cow.)
For those of you with raised eyebrow, they won’t actually be delivering a mooing, cud chewing, udder dangling live cow to your doorstep. But you will receive the delicious meat that once was that cow. And I’m not just talking about a bucket of chuck. The winners will receive sirloin, brisket, short ribs, back ribs, rib-eye steaks, T-bone steaks, NY strip steaks, Delmonico steaks, filets, bottom round roasts, center cut roasts, chuck, tongue, liver, heart, kidney, beef tallow, marrow bones, beef stock, and an oxtail. Heart and tongue not your thing? No worries. This year’s winners will get to choose exactly what they want as they’ll be receiving $1500 worth of US Wellness gift certificates they can use to order hundreds of pounds of their preferred bovine cuts – all grass fed, grass finished. Check out this Grass Fed Goodness video where you can watch your prize/meal grazing around in sweet Missouri pastures.
But winning won’t be easy. It’ll take work. And friends…
To Win the Cow, Host a Grokfeast
What’s a Grokfeast? It’s a picnic! A Primal Picnic. It involves three things:
People: At least eight.
A Feast: Food for those people. Primal food.
A Primal Activity: Fun for those people. Primal fun.
What exactly constitutes “Primal fun?” Any group form of Primal Play could work, like Ultimate Frisbee, a group hike, or Grok Tag. But less traditional options are welcomed as well. Maybe your group wants to shop a farmers’ market before the feast, or build the picnic table you eat the feast on, or host the feast on top of Half Dome. The idea is to capture the Primal spirit. Because going Primal doesn’t have to be a solo operation. Health isn’t a man alone on a treadmill; it’s a group of people enjoying each other’s company, eating healthy food, and maybe breaking a little sweat.
Check out last year’s winning Grokfeast, and all the rest from 2011 for ideas:
Grokfeast in North Carolina
Grokfeast in Monroe City, Missouri
Grokfeast in Nebraska
Grokfeast in Idaho
Grokfeast in Ontario, Canada
Grokfeast in Illinois
Grokfeast in Colorado
Grokfeast in Florida
Grokfeast in Virginia
Grokfeast in Oregon
Grokfeast in California
Grokfeast in St. Louis, Missouri
Grokfeast in San Antonio, Texas
How to Enter the Contest…
Other than having a great time, you’ll need to email me a few of your Grokfeast highlights. For a valid entry, the following are required…
A list of participants. There’s no upper limit, but the minimum is eight.
A list of dishes made for the feast and one recipe of one of those dishes (preferably the tastiest).
Photos of the Grokfeast, including at least one group shot, one shot of the feast, one shot of the recipe dish, and one shot of your Primal activity. Of course, you aren’t limited to four photos. The more pics you send us, the better!
A summary of the day. Tell us how it all went down, did something taste great? Taste awful? What was your Primal activity? Was it enjoyable? A complete failure? Did hilarity ensue? Must be at least two paragraphs. Can easily be more. But use brevity to your advantage. Writing a 15,000 word summary won’t give you a better chance at winning than someone who writes a single, well written, entertaining page.
OPTIONAL: Video of the Grokfeast. It’s not required, but certainly couldn’t hurt.
Finally, be creative! Other than keeping it Primal, there are no limitations on how to have your picnic. Did you convince your entire group to go barefoot? Did you make up your own Primal hunting/gathering game? Is your main dish a Grok-shaped meat cake? Did you have one final water balloon fight before the cold set in? Did you realize the cold had already set in and shivered miserably while building a campfire (to cook your meat on)? Did someone trap, skin, and cure a wild boar hide to use as a picnic blanket? Okay, that might be a little extreme.
But there really aren’t too many restrictions on how to do this. Whether during the day or night, by the ocean or on the roof of a parking garage, at a park, or even in Milwaukee, the possibilities are endless. And it’s not a numbers game. With coworkers, gym buddies, your college dorm cluster, eight people or eighty, the winner isn’t the group with the most people, but the group that throws the coolest Grokfeast. If your friends are all busy, remember there’s a forum filled with other Primal folks who might be in your area.
Once you’ve had your fun and gathered up the evidence, email it to me.
IMPORTANT NOTE: Include “Grokfeast Submission” in the subject line of your email. I receive hundreds of emails a day. If the subject line isn’t correct, there’s a chance I may miss your submission entirely. You can attach pictures or Word docs to the email. If you made a video, please include a link to the YouTube or Vimeo page.
Deadline for Submission:
September 24, midnight, PDT. That’s right, less than two weeks away. I said it wasn’t easy, so hustle!
How a Winner is Chosen:
While I’m not sure how many entries I’ll end up receiving, I’m going to try to publish as many as I can, if not all of them. Entries will be posted during the Reader-Created Content Week, the week of Sep. 24. Semi-finalists will be chosen by me and the Worker Bees later that week. Readers will then have a chance to vote on their favorite. The winner will be announced by the end of the Challenge, Sep. 30.
Fine Print:
In previous years, $1600 of beef was shipped directly to the winners all at once (requiring a lot of freezer space!). This year the winning contestants will receive 12 $125 gift certificates to US Wellness.
It is up to the participants to divide the gift certificates however they choose (and for those of you thinking about hoarding the beef and not telling your other participants, keep in mind your Grokfeast will be published live on a blog that gets millions of page views a month. They might find out.).
Cow prize not available to residents outside the U.S.. In the event of a non-US team winning, a prize of equal value will be sent as substitute.
MDA reserves the right to publish (or not publish as the case may be) any or all material submitted.
Only one entry per group. Only one person needs to submit the entry. That person will be used as the sole contact for prize distribution.
Depending on the number of entries, I reserve the right to adjust how and when the entries will be published and/or voted on. All rules subject to change.
To track all the contests visit the 2012 Primal Blueprint 21-Day Challenge Contest Page for daily updates.
Subscribe to the Mark’s Daily Apple Newsletter and Get Challenge Updates All Month Long

September 10, 2012
The 2012 Primal Blueprint 21-Day Challenge Begins Now

If you want to lose weight, gain muscle, reduce stress, increase energy or just generally look and feel healthier you’ve come to the right place. Oh, and you can win lots of cool Primal gear, too. That’s right, it’s the annual Primal Blueprint 21-Day Challenge!
Before we get to all the details, let’s kick things off with a simple contest. Share this blog post on Facebook, Twitter, Pinterest or by email by using one of the icons at the bottom of this post AND leave a comment in the comment board below that finishes this sentence: “My Primal Blueprint 21-Day Challenge is…”. (Example: “My Primal Blueprint 21-Day Challenge is to completely eliminate grains from my diet, and to lose 5 lbs of body fat.”) That’s it! Help spread the word about this year’s challenge and publicly commit to achieving your own health goals, and you’ll be entered to win a $200 gift certificate to PrimalBlueprint.com.
This contest ends at midnight (PST) tonight, Sep. 10. A winner will be selected at random and everyone around the world is eligible.
Now, on to the challenge details…
What Is the 21-Day Challenge and Who Is It For?
What’s the challenge? To get Primal, of course! I hold this 21-Day Challenge every year to encourage Primal beginners to give this way of eating, moving and living a try because I know it works, I know how empowering it is, and I know it changes lives.
I also do it to motivate those that have been dabbling with the Primal lifestyle for a while, but haven’t fully committed or still have some room for improvement (myself included!), to go all in and resolve to finally tackle whatever it is they want to address in their lives.
There’s something here for Primal veterans, too. It’s a good idea to revisit the basics from time to time. And hey, the chance to win free stuff isn’t half bad either.
The actual challenge itself is pretty straightforward. The details can be found in the image below. I recommend downloading the 21-Day Challenge flyer here, and clicking on the links to learn more about each of the topics. (And maybe print a few copies to hand out to friends!)
No sign-up required. Anyone can participate. Just commit to the challenge, and check back every day for motivation and guidance. Articles over the next two weeks will be about taking steps to align your lifestyle with the Primal Blueprint. The third and final week of the challenge will be entirely comprised of reader-created content. That’s right, MDA readers (you!) will be running the show. Stay tuned.
Above and beyond the challenge as outlined below, I encourage you to make your own personal challenges. Whether it’s eliminating or adding a certain food to your diet, losing weight, playing more often, getting better sleep, or anything else, customize your goals to fit your needs and commit to 21 days starting now.

Why 21 Days?
You may have noticed that this year’s challenge is a departure from the 30 day format of previous challenges. Why? After many years of training clients and interacting with hundreds of thousands of Mark’s Daily Apple readers, my team and I have found that 21 days is the sweet spot for eliminating old habits and replacing them with new ones. It’s long enough to make legitimate progress toward reversing years of adverse lifestyle habits, long enough for most people to get past the low carb flu (if you experience it at all), and long enough to give the Primal Blueprint a fair shake, but not so long as to be seen as a daunting undertaking. In other words, anyone, including you, can give this a go for three measly weeks, and in that time you are bound to see results. If you have weight to lose, it’s reasonable to expect a reduction of three to seven pounds of excess body fat during this period, and to continue at that rate safely until you reach your ideal body composition.
I’m confident that you can transform your life in just 21 days with the Primal Blueprint. So confident that I wrote an entire book about it…
The Primal Blueprint 21-Day Total Body Transformation
 This 21-day Challenge perfectly complements The Primal Blueprint 21-Day Total Body Transformation. The Total Body Transformation is all about making Primal living easy – distilling the philosophy of The Primal Blueprint (detailed in the 2009 hardcover volume) into 8 Key Concepts, 5 Action Items, and a lively 21-Day Challenge of daily endeavors in the areas of Diet, Exercise, and Lifestyle – with corresponding journal exercises. You’ll be shown exactly what to do and when to do it – eliminating any guesswork – to get and stay Primal for life.
This 21-day Challenge perfectly complements The Primal Blueprint 21-Day Total Body Transformation. The Total Body Transformation is all about making Primal living easy – distilling the philosophy of The Primal Blueprint (detailed in the 2009 hardcover volume) into 8 Key Concepts, 5 Action Items, and a lively 21-Day Challenge of daily endeavors in the areas of Diet, Exercise, and Lifestyle – with corresponding journal exercises. You’ll be shown exactly what to do and when to do it – eliminating any guesswork – to get and stay Primal for life.
If you can spare an hour a day for just 21 days, I guarantee that you will reprogram your genes and transform your life with this guidebook.
Order a copy today to enhance this year’s challenge, and for added guidance and direction.
The 21-Day Challenge Contests
The main challenge itself isn’t competitive, but that doesn’t mean we can’t have some friendly contests along they way!
Over the course of the next three weeks Mark’s Daily Apple and sponsors will be giving away thousands of dollars in prizes.
Here are some rules and answers to FAQ:
There will be new contests every day for the first two weeks (through Sep. 23) of the 21-Day Challenge, so check back daily!
All contest prizes relate in some way to the Primal lifestyle. You won’t find any miracle weight loss pills, tummy crunching sling-a-ma-doo-dads, or whole wheat health blast jazzer snackers.
Some contests will require a bit of leg work while others will require something as simple as commenting on a blog post.
There is no limit to how many contests you can participate in.
The duration of any one contest depends on the nature of the contest. Some will last a couple weeks (to give you time to complete the contest task) while others will be as short as one day. All deadlines are Pacific Standard Time.
Contest prizes will be awarded either by a random drawing, by reader voting/polling or by an executive decision (who I think should win!).
Some prizes will only be available to United States residents. If you live outside the U.S. and win a prize that can’t be shipped internationally an alternate prize of equal value will be awarded.
I’m not being paid by any company for being featured in a 21-Day Challenge contest.
To track all the contests visit the 2012 Primal Blueprint 21-Day Challenge Contest Page for daily updates.
New to the Primal Blueprint and Mark’s Daily Apple?

If you are new to the Primal Blueprint and Mark’s Daily Apple and don’t know where to begin, here are some resources to get you started:
1. Not sure what it means to “Go Primal”? Check out these articles for the basics:
The Definitive Guide to the Primal Blueprint
The Definitive Guide to the Primal Eating Plan
How to Succeed with the Primal Blueprint
2. The Primal Blueprint 101 Page
3. The Forum – I highly encourage you to use the forum during the challenge. In it you can start a “Primal Challenge Journal” to publicly state your goals and track your progress. Create a journal to receive positive feedback, advice and help along the way from the Mark’s Daily Apple community.
4. The Books
5. What to eat? – Primal Blueprint Recipes on MDA, The Primal Blueprint Cookbook and Primal Blueprint Quick & Easy Meals
6. The Newsletter – Sign up on this page to get 6 free eBooks, a 7-day course on the fundamentals of lifelong health, and more.
7. Have a question? – Contact Me
Tell your friends and family about the challenge so they can get Primal too! And don’t forget. Click the icons below to share this post, and leave a comment telling the world what you are committing to do over the next 21 days, for a chance to win a $200 gift certificate to PrimalBlueprint.com.
Subscribe to the Mark’s Daily Apple Newsletter and Get Challenge Updates All Month Long

September 9, 2012
Weekend Link Love
 Research of the Week
Research of the WeekSo a meta-analysis of around 240 studies just concluded that organic probably offers little nutritional benefit over conventional, leading to numerous “I told you so” quips and smug articles proclaiming organic to be a huge scam. But who ever thought organic was about increasing vitamin content? What about the other results of the study – the fact that conventional food tends to have upwards of 180 times more pesticide residue than organic food – that were mostly ignored by the media?
As told on a recent blog post from Suppversity, pre-workout baking soda allowed trainees to squeeze out 22 extra lower body reps.
Interesting Blog Posts
Who’s up for a toxoplasma love party? I’ll bring the infected rats and cat poop.
Anastacia from PrimalMedEd recently wrote a nice post addressing all the evidence “for” and against the saturated-fat-will-clog-your-arteries-and-murder-small-children hypothesis. Go check it out, or pass it along to anyone who subscribes to the aforementioned nonsense.
Media, Schmedia
“‘Published’ and ‘true’ are not synonyms,” claims Science Exchange, a new company that seeks to test the accuracy of published studies by attempting to reproduce their results.
P.K. Subban, a pro hockey player, follows a pretty Primal way of eating: “pretty much meat and vegetables, healthy fats” with a few yams thrown in for good measure. Oh, yeah, and there’s also the whole cow that he eats every summer.
Everything Else
Just what we need: more soybean oil-drenched battery farmed chicken in wheat!
I really like how these guys describe epigenetics. Food is information (to our cells, to our genes) about our environment.
Recipe Corner
I sometimes find that what’s good in life is a big plate of crispy marinated pork.
How about some more pork? Rellenong talong, or pork-stuffed eggplant.
Time Capsule
One year ago (September 9 – September 16)
Listening to Your Body – It’s always trying to tell you all sorts of stuff, but are you listening?
Why Self Experimentation Matters – It’s ultimately the only way to get study results that definitely apply to you. Plus, access to the full text is usually free.
Comment of the Week
This is definitely an article for me. I’ll be sure to read it later.
- Well done, Moshen. I was expecting (and received) a deluge of similar comments, but the simplicity of yours really worked. I wonder, though – did you ever end up reading?
Grab The Primal Blueprint Cookbook Today and Receive Free S&H and a Free Primal Blueprint Poster

September 8, 2012
Shortcut BBQ Ribs
 Sharing a recipe for pork ribs is risky business. First, there’s the matter of flavoring the meat. Is a rub, a marinade, or a sauce the superior flavoring method, or maybe some combination of the three? And forget about finding a rub that all rib lovers agree on. There are hundreds of rub blends, all slightly different from the others, with each cook claiming their spice rub is the best.
Sharing a recipe for pork ribs is risky business. First, there’s the matter of flavoring the meat. Is a rub, a marinade, or a sauce the superior flavoring method, or maybe some combination of the three? And forget about finding a rub that all rib lovers agree on. There are hundreds of rub blends, all slightly different from the others, with each cook claiming their spice rub is the best.
Once you finally commit to a seasoning method, then you’ve got to cook the ribs. This is the part that can be really intimidating. Ribs can be cooked on a regular grill, but serious rib lovers invest in a smoker. Cooking ribs can easily take half the day, most of it spent slowly grilling, flavoring and obsessively coaxing the ribs to tender, smoky perfection.
Ribs cooked long and slow in a smoker or charcoal grill are delicious. There is no debate about that. But let’s be honest. Not everyone has a smoker and very few people have five hours to devote solely to cooking dinner. If you’re someone who loves ribs but you want to bypass all the intricate cooking steps and just get the ribs on the table, this quick and dirty method is for you.
Serious rib aficionados, avert your eyes. The rest of you, keep reading because you’re going to love these tender, crispy, fatty, deeply flavorful and easy-to-make ribs.
The trick is steaming the ribs in the oven before they hit the grill. The ribs come out of the oven tender with their glorious meaty, fatty flavor still intact. From there, they need just a little bit of time on the grill to finish cooking, and for a crispy, lightly charred coating to form. Before throwing them on the grill, you can season the ribs anyway you like. The rub here is bold and mildly spicy, with smoked paprika and cumin leading the charge.
For very little time and effort, you’ll be rewarded with big flavor and tender juicy, crispy meat. What more could you want from a rib?
Ingredients:
2-3 racks pork ribs (either St. Louis (a little meatier) or baby back ribs)
2 teaspoons black peppercorns (10 ml) (or 1 teaspoon ground pepper)
2 teaspoons cumin seeds (10 ml) (or 1 teaspoon ground cumin)
1/2 teaspoon Chinese Five Spice (2.5 ml)
2 tablespoons smoked paprika (30 ml)
1 tablespoon regular paprika (15 ml)
2 teaspoons garlic powder (10 ml)
1/2 teaspoon kosher salt (more if the garlic powder contains no salt) (2.5 ml)
2 tablespoons Dijon mustard (30 ml)
Instructions:
Some ribs will still have the membrane attached, the thin white layer on the bone side of the rack. You can leave the membrane on, which can make the ribs slightly less tender, or you can remove it. Start at one end of the rack and use a knife to peel up the membrane along the last bone. Peel the entire membrane up slowly.
Preheat the oven to 300 °F (149 °C).
Wrap the ribs in a foil tent, either individually or side by side in a very large foil tent. Leave a little opening and pour 1/3 cup of water into the foil tent. Tightly close the foil so no steam can escape. You want the foil to be secure so the water doesn’t leak out, but leave the top of the foil tented up so steam can circulate.
Set the ribs in a rimmed baking pan. Bake 1 hour. Take the ribs out of the oven and let sit, without loosening the foil, for 45 minutes to further steam the meat.

If using whole peppercorns and cumin seeds to make the rub, toast the peppercorns and cumin seeds in a dry skillet over medium heat, 2-3 minutes. Let cool, then blend in a coffee grinder until smooth. Mix with the Chinese Five Spice, paprikas, garlic powder and salt.
Open the foil packet and rub the ribs with mustard then rub them down with 3 tablespoons of the spice rub. In another bowl, mix the remainder of the spice mix with about 1/3-1/2 cup of water to make a watery rub that you can mop the ribs with as they cook.
Heat either a charcoal (ideally) or gas grill to medium heat. Keep a section of the grill where you can cook the ribs with indirect heat, meaning the ribs are not directly over a flame.
Place the ribs on the grill, meaty side down.
At this point, the ribs are essentially cooked and you’re just finishing them off and getting them good and crispy on the outside. If the grill is too hot or the ribs are directly over a flame, the spice rub will burn and the meat won’t be as tender. Keep an eye on the ribs as they cook, turning and brushing them with the liquid spice rub occasionally.

Depending on how hot your grill is, total cooking time is likely to be between 20-40 minutes.
A good way to tell if the ribs are done is to take a fork or pair of tongs and twist one of the ribs on the end of the rack. It should separate from the rack fairly easily. The outside should be crispy and caramelized, but not burnt.

Grab The Primal Blueprint Cookbook Today and Receive Free S&H and a Free Primal Blueprint Poster

September 7, 2012
Overcoming the Insurmountable
It’s Friday, everyone! And that means another Primal Blueprint Real Life Story from a Mark’s Daily Apple reader. If you have your own success story and would like to share it with me and the Mark’s Daily Apple community please contact me here. I’ll continue to publish these each Friday as long as they keep coming in. Thank you for reading!
 Mark,
Mark,
I never thought I would be writing or sharing a success story. Not because I didn’t’ think there would be success, but because I am really not the sharing type. But what happened to me and my wife is important, and I want you to know. I have been telling anyone who will listen:
First, a little background. I was and still am an active person. I used to work out daily at the gym for an hour, played hockey twice a week and was an avid skier, but I was really starting to loathe my workouts. I ate well, or at least I thought I did, but I also had a sweet tooth and we had no shortage of cookies, candy and everything in-between stocked in the pantry. I would go through phases of what I would call the Atkins diet if I felt I was getting too flabby. I would cut out refined sugars, bread and pasta, but was still keen on items like Diet Coke and anything a grocery store would classify as meat. My weight and body composition fluctuated regularly.
I didn’t know I was looking for an alternative, but fortunately I found one shortly after reading Born to Run. I was doing some Google searches on barefoot running, and sure enough Mark had an article on the subject. I think I bought the book the next day and not too long after that started making some very positive changes to my diet, my exercise routine and my lifestyle because I now understood what I needed to do and WHY!!!!! And I am happy to stay I’ve not only stuck to it, but I have been a good influencer for others and that is where this story gets interesting.
I am married and the proud father for 6-year-old twin girls. Twin girls that came to us through extensive time, energy and money spent at one of the top fertility clinics in the country. My wife suffers(ed) from Polycystic ovary syndrome (PCOS) which is one of the most common female endocrine disorders. As you’ll find on Wikipedia and can verify elsewhere:
PCOS produces symptoms in approximately 5% to 10% of women of reproductive age (12–45 years old). It is thought to be one of the leading causes of female subfertility and the most frequent endocrine problem in women of reproductive age.
The principal features are anovulation, resulting in irregular menstruation, amenorrhea, ovulation-related infertility, and polycystic ovaries; excessive amounts or effects of androgenic (masculinizing) hormones, resulting in acne and hirsutism; and insulin resistance, often associated with obesity, Type 2 diabetes, and high cholesterol levels. The symptoms and severity of the syndrome vary greatly among affected women.
We always wanted to have another child but the thought of going through the required process – which includes a heavy load of hormone drugs and the 25% chance of twins – seemed like too much for my wife and too much for our family. We essentially made the conscious decision that we were done! Or were we?….
In Dec 2011 I was finally able to convince my wife that it was time for her to make some lifestyle changes as well. She was very aware of the positive results I had been experiencing, but lacked the understanding, as I had, to make the changes needed. I gave her my copy of the PB and the next day we emptied our house of all the “bad food” and she was off and running down the Primal path. Little did we know that the path would take us to a growing family. My wife’s menstrual cycle quickly normalized when she eliminated unnecessary grains, gluten and sugar from her diet. In March, 3 months after going Primal, she became pregnant with our third child.
We had no idea this would happen and we are thrilled (and surprised). I wanted to say thank you because you have provided us the knowledge and given a lot of guidance – making it very easy to make what seems an insurmountable change.

warm regards,
Jeremy Creed
Grab The Primal Blueprint Cookbook Today and Receive Free S&H and a Free Primal Blueprint Poster

September 6, 2012
A Primal Primer: Candida
It’s been awhile since I’ve done one of these, but I think it’s about time for a Primal Primer. Today we’ll be discussing candida, a genus (more than a species, less than a family) of yeast with many members, at least one of which is currently residing on or in your body: candida albicans. Candida albicans and friends are everywhere, and they’re usually a normal, healthy part of the human microbiome, but it can get a little out of hand. As I’ve mentioned before, the human gut hosts a tumultuous mix of microbial species vying for position and supremacy and trying to further their own ends. If all’s well, a balance is maintained, and the various species keep each other in check while promoting good health for the human host. But things can get out of whack. The balance can be upset. Certain species can gain ground on the others, perhaps by utilizing a new source of sustenance or taking advantage after a round of antibiotics, to our detriment. Candida is a particularly robust microbe who can thrive on a variety of fuel sources to apparently make itself a real nuisance in these situations. Let’s take a closer look, shall we?
It’s been awhile since I’ve done one of these, but I think it’s about time for a Primal Primer. Today we’ll be discussing candida, a genus (more than a species, less than a family) of yeast with many members, at least one of which is currently residing on or in your body: candida albicans. Candida albicans and friends are everywhere, and they’re usually a normal, healthy part of the human microbiome, but it can get a little out of hand. As I’ve mentioned before, the human gut hosts a tumultuous mix of microbial species vying for position and supremacy and trying to further their own ends. If all’s well, a balance is maintained, and the various species keep each other in check while promoting good health for the human host. But things can get out of whack. The balance can be upset. Certain species can gain ground on the others, perhaps by utilizing a new source of sustenance or taking advantage after a round of antibiotics, to our detriment. Candida is a particularly robust microbe who can thrive on a variety of fuel sources to apparently make itself a real nuisance in these situations. Let’s take a closer look, shall we?
When most people talk about “candida,” they’re talking about candida overgrowth, or candidiasis, of which there are several types:
Candidal vulvovaginitis – Also known as vaginal thrush or yeast infection, this is a fairly common manifestation of candidiasis that causes pain during sex and urination, itching, redness, swelling, and/or vaginal discharge.
Candidal keratitis – Candidal infection of the eye.
Esophageal candidiasis – Candidal infection of the esophagus
Intestinal candidiasis – Overgrowth in the small intestine. This is the “candida” people are usually talking about.
Candidemia – This often fatal condition involves the presence of large numbers of candida yeast in the blood and typically arises only in severely immunocompromised patients.
Conventional medicine has yet to formally recognize candidiasis as an issue prevalent enough to seriously study. On one hand, I understand their hesitancy, as candida has become a catch-all explanation for dozens of symptoms online, some of which may or may not be interrelated. On the other hand, gut dysbiosis is a real condition with huge – if as yet to be completely understood – ramifications to our health. We have some idea of what is going on in our guts and how it all impacts our health (especially with regards to obesity and immunity), but the field is still in its infancy. Eventually, thanks to programs like the Human Food Project, we’ll have a stronger understanding. For now, we work with what we have. I seriously doubt claims like “99% of all people have candida overgrowth,” but I have an open mind, and if people are feeling awful and getting no relief from their doctors’ attempts to help, it makes sense to expand your search. Right?
One researcher even went so far as to orally inoculate himself with candida (he ate a very large dose of it) to find out of it was capable of colonizing his gut and entering his blood (PDF). Two hours after inoculation, he experienced chills and a headache. At hours 3 and 6, candida was cultured from his blood, and at hours 2.75 and 3.25, from his urine. The researcher was otherwise healthy, hadn’t used antibiotics in ten years, and had no preexisting yeast infections. This is but one example, but it suggests that candida in sufficient amounts can make it to the gut and through the intestinal wall, even in healthy people.
Diagnosis
Since the existence of intestinal candidiasis isn’t universally accepted among medical professionals, it makes diagnosis difficult to obtain. “Endoscopic brushings” (sounds pleasant, doesn’t it?) have been used in the past, as have stool cultures. You might read about the “candida spit test,” which involves depositing fresh saliva into a glass of water upon waking and observing its trajectory and behavior, but this doesn’t appear to be accurate. Further complicating matters is that dozens of candida species exist, even though most of the already limited research has focused on candida albicans. Still further, research suggests (PDF) that chronic candida overgrowth is almost impossible to fully diagnose with lab tests that measure immune response, since it often downregulates the immune system, thereby creating an “immunologic tolerance.” Thus, symptoms may be the best we have, especially if we can’t get our doctor to run a stool test.
Symptoms
Unfortunately, going by symptoms can also be confusing, because candida overgrowth appears to have dozens of them, like headaches, fatigue, chills, feeling drunk or hung over, a lack of libido, weight gain, weight loss, food intolerances, bloating, joint pain, diarrhea, hair loss, gas, cravings, and depression. Just go to Google and search for “candida and [enter malady or symptom of your choice].” It’ll autofill before you can even finish typing and hitting enter will bring up tons of articles telling you that “yes, you are indeed experiencing symptoms of candida.” See the problem? Any negative feeling or symptom could be evidence of candida.
This doesn’t negate the reality of candida overgrowth nor its symptoms, but it does make figuring out whether you have it extremely difficult. It also makes an incorrect diagnosis fairly likely, since many of those symptoms can also have other causes.
Risk Factors
While absolute causes of candidiasis are tough to pin down, looking at some of the common risk factors for the condition can give us a hint. What are they?
Antibiotic usage
You know the drill here. We’ve discussed how antibiotic usage (especially flagrant, excessive usage) can have a “collateral damage” effect on “innocent” gut microbes in addition to the target microbes. We’ve also discussed how the delicate balance of gut flora can be disrupted, thereby opening up space for existing species to flourish and overpopulate. Antibiotics represent a potent disruptive force in the gut, and antibiotic usage has been linked to both candidal vulvovaginitis (yeast infections) and systemic candidiasis. Patients with antibiotic-associated diarrhea are often found to have greater levels of candida in their stool. One girl even developed an overgrowth of intestinal candida immediately following antibiotic treatment.
Diabetes
Diabetes is consistently linked to candida overgrowth, women who have diabetes are more likely to have recurrent vaginal yeast infections, and patients with elevated blood sugar (as is often seen in diabetes) are more susceptible to candida overgrowth, probably due to the yeast’s taste for glucose.
Immune dysfunction or suppression
Patients with poor immune systems, like those with HIV/AIDS or undergoing chemotherapy, are at a greater risk of candida overgrowth.
Treatment
First and foremost, if you indeed have a serious candida overgrowth, it’s a complicated issue that may require a professional’s attention and the use of anti-fungals, like nystatin, fluconazole, or anidulafungin. Unfortunately, as with bacteria and antibiotics, candida often develops resistance to anti-fungals (PDF), which may explain why treatment can be so frustrating and seemingly ineffective. Seek help if you’re really suffering.
That said, I’m no expert on candida, and I have neither the desire nor the ability to coach you through an overgrowth. However, the following “treatments” are generally pretty safe to try, and, even if you don’t have candida overgrowth, may result in health benefits. If you just suspect you have an overgrowth of candida and have no formal diagnosis, giving these ideas a try can’t hurt.
Avoid sugar and limit fruit.
Candida likes sugar (who doesn’t like sweets?) because it represents a quick food source. It’s also a fairly reliable source of energy, since most people are more than happy to pump themselves full of refined sugar. Fruits should be less problematic, but stick to lower sugar fruits and keep a close watch on how it affects your symptoms.
Avoid very low carb.
Paul Jaminet, who suffered from candida overgrowth, argues that since candida (being eukaryotes) have mitochondria that can feed on both ketones and carbs (as opposed to prokaryote bacteria without mitochondria), going very low carb or ketogenic will only provide more fuel for the overgrowth. Furthermore, since ketones are water-soluble and pass easily through cellular membranes, ketones will actually be a more accessible food source for candida. Don’t go high-carb, since any extra glucose will just be food for the yeast, but don’t go ketogenic, either. Stick to around 100-150 grams of carbs while still limiting sugar. Although other sources do recommend going as low-carb as possible, my money’s on Paul.
Consider a saccharomyces boulardii supplement.
S. boulardii has proven effective against candidal overgrowth, reducing both the resultant inflammation and the colonization of the gut. It appears that the capric acid released by s. boulardii deserves praise here, seeing as how it prevents growth, adhesion to the host, and formation of resistant candida biofilms. Coconut oil, another source of capric acid, has also been shown to inhibit candida in an in vitro study, but it will also promote the generation of ketone bodies, which may serve as fuel for the candida. Your call; they’re available online.
Use more spices and herbs.
Since plants often have to deal with pathogenic fungi, many spices and herbs have developed anti-fungal capabilities. Cumin spice exerts antimicrobial activity against candida. Oregano is a famous anti-fungal herb, and garlic has proved efficacious against candida biofilms in in vitro studies (and may even work synergistically with anti-fungal drugs against drug-resistant candida species). When you start getting into essential oils of the various plants, however, use caution, as these are highly concentrated and may be more powerful than you or your body are prepared to handle. Personally, unless you’re under the observation of a skilled medical professional, I’d stick to the whole plants and herbs. You might try drinking some strong black tea, too.
Ibogaine?
Even ibogaine, the psychoactive plant compound that William S. Burroughs went looking for to cure his heroin addiction, exhibits some effectiveness against candida. I’m not suggesting you rush out and find yourself an ibogaine tour to Gabon, but it’s still pretty interesting.
Die-off?
Formally known as the Herxheimer reaction, negative health effects – like headaches, fever, chills, and pain – resulting from microbial die-off are a real occurrence. When antimicrobials are administered to take care of certain infections, including syphilis, borreliosis (from Lyme disease), leptospirosis, Q fever, cat scratch fever, brucellosis, typhoid fever, and trichinosis, certain inflammatory cytokines are upregulated. It has been argued that endotoxins released from dying microbes are the cause of die-off symptoms, but studies call that into question.
Note that the existence of candida die-off has yet to be shown. Given that die-off exists for other microbial infections, however, I think it’s fairly plausible. What I find questionable is when every negative symptom under the sun is proclaimed to be die-off. Feverish chills? Okay, I’ll buy it. A slight headache and a weird headspace? Sure, that’s reasonable. Violent convulsions punctuated by frothy spurts of blood-flecked vomit? Eh, I think that might be something other than “candida die-off.” You might want to get that checked out.
It’s difficult to say anything absolutely conclusive about candida overgrowth. There’s no standard, easily-accessible test for it. There are so many signs and symptoms that they almost become useless for diagnosis. There are many species of candida, many species of other yeasts, and some candida can even be helpful in the right doses! However, even though it’s hard to get a doctor to test for it (if he or she even knows how) and it’s hard to know if you even have it, it looks like candida overgrowth is a real condition. Whether its prevalence is under- or overstated, though, we simply don’t know.
What do you know about candida? Have you had it? Do you think you do currently? If you’ve ever been treated for it, how’d you know it was actually candida? This is a hot topic in the health world, rife with misinformation on both sides of the debate, so let us know what you know in the comment section!
Get the Primal Blueprint Fitness eBook, Free Health Tips and Primal Recipes Delivered to Your Inbox

September 5, 2012
How Common is Gluten Sensitivity?
 I’ve long suspected that everyone has some degree of sensitivity to gluten, even if they’ve never been formally diagnosed and even if they don’t notice any overt symptoms after eating it. Now we have concrete evidence that non-celiac gluten sensitivity actually exists. My own story was that of a lifetime grain-eater who defended my “right” to eat grains until I was 47 – until the evidence was just too overwhelming to ignore. Once I gave them up as part of a 30-day experiment, lo and behold, my arthritis cleared up, my lifelong IBS went away, and my occasional GERD disappeared. Ditching grains, especially wheat, changed my life for forever and made me understand how easy it is for so many people to overlook this possible problem. A recent study, which I highlighted in Weekend Link Love, confirmed the existence of non-celiac wheat sensitivity. Subjects without the atrophied villi (tiny projects that line the intestines and help absorb nutrients) characteristic of celiac and without positive tests for various markers that indicate celiac experienced gluten-related symptoms after a blinded wheat challenge. It doesn’t give us much of a clue as to the prevalence of sensitivity, but it establishes that such a thing might exist among the general population.
I’ve long suspected that everyone has some degree of sensitivity to gluten, even if they’ve never been formally diagnosed and even if they don’t notice any overt symptoms after eating it. Now we have concrete evidence that non-celiac gluten sensitivity actually exists. My own story was that of a lifetime grain-eater who defended my “right” to eat grains until I was 47 – until the evidence was just too overwhelming to ignore. Once I gave them up as part of a 30-day experiment, lo and behold, my arthritis cleared up, my lifelong IBS went away, and my occasional GERD disappeared. Ditching grains, especially wheat, changed my life for forever and made me understand how easy it is for so many people to overlook this possible problem. A recent study, which I highlighted in Weekend Link Love, confirmed the existence of non-celiac wheat sensitivity. Subjects without the atrophied villi (tiny projects that line the intestines and help absorb nutrients) characteristic of celiac and without positive tests for various markers that indicate celiac experienced gluten-related symptoms after a blinded wheat challenge. It doesn’t give us much of a clue as to the prevalence of sensitivity, but it establishes that such a thing might exist among the general population.
It’s not even the only study. It’s just the latest of many to establish and/or hint that non-celiac gluten sensitivity exists:
“Spectrum of gluten-related disorders: consensus on new nomenclature and classification.” (2012)
“Gluten causes gastrointestinal symptoms in subjects without celiac disease: a double-blind randomized placebo-controlled trial.” (2011)
“Is gliadin really safe for non‐coeliac individuals? Production of interleukin 15 in biopsy culture from non‐coeliac individuals challenged with gliadin peptides.” (2007)
But how prevalent is it? We know that celiac disease is on the rise; what about gluten sensitivity?
First, before we get into numbers, let’s go over the difference between celiac and gluten sensitivity:
Celiacs have persistent and profound perforation of the intestinal lining (at least as long as they’re eating gluten) as well as atrophy of the villi, thereby allowing foreign proteins – including, but not limited to, gluten – constant access into the bloodstream and impairing nutrient absorption. Folks with “mere” gluten sensitivity have transient and milder intestinal permeability, or sometimes none at all.
Celiac is an autoimmune disease that inspires the immune system to attack the body’s own tissues, while in gluten sensitivity, the immune attacks are directed solely against components of the diet (gliadin).
Celiac disease seems to involve the “adaptive immune system,” while gluten sensitivity involves activation of the “innate immune system.”
In celiac, the inflammatory cytokine IL-17 is elevated. In gluten sensitivity, it is not.
So gluten sensitivity and celiac disease are two distinct “clinical entities” with the same environmental trigger – gluten – and many of the same symptoms:
Diarrhea
Bloating
Abdominal pain
Eczema
Headache
Foggy brain
Fatigue
Depression
Joint pain
Numbness in the extremities
And sometimes the symptoms aren’t obviously connected to gluten (or anything you did or ate). It’s tough to ignore persistent diarrhea that precipitates (pun intended) upon gluten ingestion. That’s an obvious symptom that may clue you in, especially if you’re aware of the potential problems with gluten, you’ve just eaten something containing it, and you’re pondering all this while filling the toilet. But gastrointestinal symptoms don’t always present themselves in gluten sensitivity, as in this study, where 13% of subjects with gluten ataxia (a kind of neuropathy) had no GI symptoms. I mean, who hasn’t felt brain fog from time to time, or been tired in the middle of the day, or had some itchy rashy red skin, or had sore joints before? Most people would never think to link these to the bagel they just ate (ok; you guys might).
Testing for gluten sensitivity is tough because there’s no real standard yet. You’ll notice that the recent study didn’t determine gluten sensitivity solely by running patients’ labs and looking for a certain figure; they had to painstakingly and laboriously eliminate confounding variables (like celiac) through extensive lab testing, and then run a double blind wheat challenge to see if symptoms still arose. That grand, single overarching lab test doesn’t exist, not yet anyway.
Well, that’s not exactly true. There are tests that measure the presence of anti-gliadin IgA (a gliadin antibody) in the blood and in the stool. Antibodies in the blood mean that gliadin made it through the intestinal lining into the blood, where the body mounted a defense against it; antibodies in the stool indicate the presence of antibodies in the gut, where the body has mounted a defense. Gut antibodies, however, come before blood antibodies. For that reason, fecal antibody tests are regarded as more accurate for testing gluten sensitivity, because blood antibodies only show up after significant intestinal damage has allowed gliadin to pass through. You could test positive for fecal antibodies and negative for blood antibodies if your intestinal lining remained fairly intact.
One study found that around 12% of healthy people’s blood samples tested positive for antibodies to IgG. Fecal tests, however, indicate that around 29% of healthy people test positive. If the fecal antibody tests are accurate and reflective of gluten sensitivity, that’s nearly a third of Americans!
There’s also a genetic component to gluten sensitivity and celiac, the HLA-DQ gene. According to some reports, almost every permutation of the HLA-DQ gene is associated with some manner of gluten sensitivity, particularly the haplotypes HLA-DQ2 and HLA-DQ8. Only HLA-DQ4 has never been linked to any form of gluten sensitivity, and less than 1% of the American population possesses a homozygous HLA-DQ4/4. If that holds true, then the vast majority of Americans have the genetic potential toward gluten sensitivity.
Of course, when you consider that everyone – regardless of genetic proclivity toward autoimmunity – releases zonulin, the regulator of intestinal permeability, when our intestinal lining is exposed to gliadin (a component of gluten), a universal response to gluten looks likelier. Sure, we all know plenty of people who can eat a sandwich without complaining, or that guy who claims he could never live without wheat. Gluten and related fragments may be getting through the intestinal lining in these people, but their immune systems mop them up pretty handily before they can do much damage. But what happens if their immune system is impaired, maybe because of a period of chronic stress or overtraining? What happens if their microbiomes are ravaged by antibiotics and poor diet and thereby absent the bacterial species necessary to fully degrade gluten? There’s no clinical trial tracking the effects of usually healthy people undergoing chronic stress or antibiotics on their sensitivity to gluten, but people are stressed, people are overworked, and their guts are messed up. It’s hurting our health in many different ways, and I wouldn’t be surprised if there is a lot more undiagnosed gluten sensitivity out there because of it.
It’s conceivable that gluten could be doing damage and causing constant, low-grade inflammation without you even knowing it. This is why folks who go Primal and give up wheat and other gluten-containing grains become more “sensitive” to wheat upon reintroduction. It’s not that going Primal has suddenly made them intolerant of gluten; it’s likelier that going Primal has made them more sensitive to their gluten sensitivity. It was probably always there, but they never knew what they were feeling until they removed it and then tried to reintroduce it.
As for figuring out if you’re gluten sensitive, I suppose you could go for one of the stool or blood tests provided by EnteroLab or Cyrex Labs (although not everyone is enamored with EnteroLab). But honestly? The gold standard is to just not eat gluten for a few weeks to a month and then reintroduce it and see how you feel. If any strange symptoms pop up (see list above), you’re probably sensitive to gluten. If you want further clarification at this point, then go for the tests. Just try the diet first. It’s gonna be your best (and probably the only necessary) lens.
We don’t have any real solid answers, sadly, just hints. But isn’t that how questions of human physiology tend to play out? It might be 12%, or maybe 30%, or perhaps even a higher (or lower) percentage of the population. Whatever the number, I know that grains don’t serve me well, and they probably aren’t doing you any favors either. So try giving them up for 30 days and seeing how you feel. After all, you aren’t missing out on anything nutritionally by avoiding gluten, except for some potential nasty health issues down the line.
That’s what I’ve got, folks. What do you think? Are you gluten sensitive? Let me know in the comments, and thanks for reading!
Grab The Primal Blueprint Cookbook Today and Receive Free S&H and a Free Primal Blueprint Poster

September 4, 2012
Is It Primal? – Chia Seeds, Black Rice, Refined Avocado Oil, and Other Foods Scrutinized
 The questionable foods just keep flowing in. As soon as I write a new “Is it Primal?” post, I’m inundated with new stuff to scrutinize. It’s like cutting the heads off the hydra (speaking of which, what are the nutritional qualities of hydra? talk about a sustainable animal food source). Luckily I like writing these posts, so they are probably here to stay. I hope you enjoy them. Well, let’s get on with it, shall we?
The questionable foods just keep flowing in. As soon as I write a new “Is it Primal?” post, I’m inundated with new stuff to scrutinize. It’s like cutting the heads off the hydra (speaking of which, what are the nutritional qualities of hydra? talk about a sustainable animal food source). Luckily I like writing these posts, so they are probably here to stay. I hope you enjoy them. Well, let’s get on with it, shall we?
Today we’ll delve into the sordid inner world of the chia seed (of Chia Pet fame, yes), the dark underbelly of black rice, the hidden agendas of the refined avocado oil consortiums, the Communist North Korean plot to brainwash minds via sweet potato vermicelli consumption, and how strawberries might actually be trying to kill you (yeah, strawberries). Actually, we’ll just figure out if said foods are Primal or not.
Let’s go:
Chia Seeds
Even though I’ve written about chia seeds already on two separate occasions, people keep asking me about them. So, to start with, read those two posts. They’re high in plant omega-3, ALA, which, according to most evidence, we humans are not great at converting into EPA and DHA, the long chain omega-3s that our bodies truly require. However, I’d like to add a couple new thoughts to the subject:
There’s some recent evidence that moderately-longish term chia seed supplementation (7 weeks long) can actually increase plasma ALA and EPA levels in postmenopausal women. That ALA increased isn’t a surprise, since ALA is the predominate fat in chia, but the 30% EPA increase was a bit of a shock. Perhaps the conversion rate can be higher (although DHA levels slightly decreased). It’s worth noting that these were milled chia seeds, which are easier to digest (and, presumably, absorb the nutrients within) than whole seeds. That could have had a measurable impact.
I’ve been down on fiber in the past. Still am, in fact, provided you’re talking about insoluble, bowel-rending, toilet-bowl-filling fiber. But soluble fiber? Fiber that feeds the gut flora? Fiber that actually promotes gut health? Fiber that gets fermented into short chain fatty acids with a host of health benefits? I’m okay with that kind of fiber, and chia seeds have plenty of it. However, since soluble fiber is “active” in your gut, it can cause gastrointestinal distress, especially if you aren’t used to eating plant matter rich in the stuff.
Verdict: Primal, but be wary of any superfood claims (unless they’re talking about liver and pastured egg yolks), closely monitor your fiber tolerance, and don’t rely on them for your omega-3s.
Black Rice
In previous posts, I’ve suggested white rice as a fairly inoffensive grain. As grains go, rice ranks close to suitable. I don’t recommend its consumption for everyone, at any time, but it can be a valuable arrow in the quiver of the hard-charging athlete in need of dietary glucose, and no longer fearing white rice can definitely make dinner at your favorite sushi joint that much more enjoyable. But what about black rice?
Black rice is actually closer to purple than pure black, with a slightly sweet flavor that lends itself to coconut milk desserts. It is similar to brown rice in that it retains the bran, which means it retains lots of the nutrients, but also lots of the antinutrients. Of course, rice is fairly nutrient-and-antinutrient-sparse either way you go, with few lectins and no gluten, but there is a fairly significant amount of phytic acid in the bran. This website indicates that black rice bran is known for its considerable phytic acid, although I wasn’t able to obtain a solid figure. At any rate, I’d be willing to wager that black rice is also similar to brown rice in that proper fermentation eliminates almost all of the phytic acid (96% of it!), so if you’re willing to do the work, the negatives can be mitigated.
Yeah, yeah, that’s a lot of work, though. Couldn’t I just eat white rice, or, you know, a sweet potato if I was interested in glucose? True, but consider that in nature, color tends to mean polyphenols. Brightly colored fruits and vegetables are notorious repositories of antioxidants, and black rice – though not a vegetable – is no different. In fact, the anthocyanin content of black rice rivals that of the blueberry. Anthocyanin, also found in other darkly colored fruits and vegetables like red grapes, blackberries, and purple sweet potatoes, display dozens of beneficial health effects.
Verdict: Not Primal, but if you’re willing to soak and ferment it, it can be a potentially healthy way to get some glucose and polyphenols in your body.
Refined Avocado Oil
As I’ve mentioned before with regards to coconut oil, not all refined oil is unhealthy.
Interestingly, refined avocado oil is even more oxidatively stable than unrefined avocado oil, and this difference in stability comes primarily down to the difference in chlorophyll content. That is, the chlorophyll in unrefined avocado oil – it’s what makes it green (and admittedly attractive) – reacts with light to form oxidation products. Refined avocado oil, which is a pale yellow bordering on clear, contains almost no chlorophyll and shows essentially zero traces of oxidation – 0.1% free fatty acids (in order to qualify as “extra virgin” in the eyes of the International Olive Council, olive oil must register below 0.8%) and a peroxide value of 0.1 mEq/kg (the IOC demands less than 20 mEq/kg of its extra virgin olive oils).
With a neutral flavor, a similar fatty acid profile to olive oil - 70% MUFA, 12% Omega-6 PUFA, 1% Omega-3 PUFA, 12% SFA – and a smoke point suitable for high heat cooking, refined avocado oil can be a useful addition to your Primal kitchen.
Verdict: Primal, so long as you’re using expeller-pressed refined avocado oil.
Korean Sweet Potato Vermicelli
I love sweet potatoes. If I’m going to eat some starch, chances are I’ll reach for a sweet potato. Maybe it’ll be a purple Okinawan. Maybe it’ll be a Japanese white. Maybe it’ll be an orange garnet yam, or a classic yellow sweet potato. Whatever it is, it’s probably a slightly sweet tuber. Why, you might ask?
They’re delicious. They’re loaded with minerals (especially potassium), antioxidants, and vitamins. They’re “cellular carbohydrates,” starches made up of actual, cohesive cells, as opposed to “acellular carbohydrates,” which a recent paper (PDF) fingers as a potential cause of the obesity epidemic. That paper’s a great read, by the way.
But sweet potato noodles are not quite sweet potatoes. They’re made up of sweet potato amylopectin, the fast-digesting, fast-absorbing starch that’s been connected with the development of insulin resistance. Sweet potato starch is just that – starch. It doesn’t have the fiber or the micronutrients. Heck, sweet potato starch noodles don’t even look like they’re made from sweet potatoes; in their uncooked state, they’re dull, grey lifeless looking things. And since it’s been dried and extracted and pounded into oblivion, sweet potato starch is a prime example of an acellular carbohydrate, a dense carbohydrate that may promote an inflammatory intestinal microbiome (like I said, read the paper!).
That doesn’t mean you can’t have a little dish of acellular carbs now and then, especially if your training and your glucose tolerance support their consumption. Just don’t make them a staple if you’re trying to lose weight. Don’t have soybean oil stir-fried sweet potato vermicelli just because it’s from a “safe starch”. Don’t think the fact that they come from sweet potatoes will make any difference to your insulin resistant body.
Verdict: Not so Primal.
Strawberries
You might be wondering: why are strawberries even deserving of scrutiny? I mean, these are berries, the fruit that pretty much everyone agrees is good for you. You get Dean Ornish, Gary Taubes, one of the banana fetishists, Sally Fallon, and any Primal or paleo person in a room and, once the dust has settled, each and every one of those people will nosh on some strawberries.
Well, a reader asked a question. When that happens, I like to answer, especially when it concerns the strawberry. The reader had heard that before the 19th century, the strawberry was a small, sour, oft-ignored wild fruit that no one really cared about until an enterprising farmer decided to breed the sweetest ones for several generations, eventually ending up with what we know and love today. If that was the case, and the modern strawberry is a recent “invention,” shouldn’t we scrutinize its place in the modern Primal fruit platter?
Sure, let’s scrutinize. References to the strawberry date back into antiquity; in one of his writings, Pliny the Elder counts it among the natural products of Italy, while Ovid’s Metamorphoses contain a reference to “the soft strawberries growing beneath the woodland shade.” By 1300, the strawberry was being formally cultivated in Europe, by 1597, Shakespeare was dropping lines about strawberries into Richard III (I know, I know, Shakespeare liked to coin phrases, but I don’t think he coined the strawberry), and by 1820, what was once just three varieties of strawberry had ballooned into thirty.
I’ve had wild strawberries, and they’re small, sure, you can’t dip them into chocolate too well, of course, and the stems are longer than the berry, but they are sweet and tasty nonetheless. As for nutritional differences, wild strawberries are generally higher in antioxidants than cultivated strawberries (probably because they deal with a lot of oxidative stress out in the great outdoors). I’m not sure this matters a ton, however, since cultivated strawberries still rate higher than other fruits like kiwi, apples, apricots, and peaches. Plus, a recent study found that strawberries activate a uniquely beneficial antioxidant pathway in those who eat them, and I’m pretty sure they used cultivated strawberries.
Verdict: Primal.
Thanks for reading today, folks. I hope you learned something. Let me know your thoughts on these foods (and any other foods you’ve been wondering about) in the comment section!
Grab a copy of Primal Blueprint Quick & Easy Meals for over 100 Primal Recipes You Can Prepare in 30 Minutes or Less

Mark Sisson's Blog
- Mark Sisson's profile
- 199 followers




